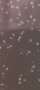
Моини.Стартова култура. , снимка 3

Капка Каменова
В Bazar.BG от 12 юни 2025г.
Последно активен
вчера в 05:23 ч.
Моини.Стартова култура. → Обява 51485068
Моини.Стартова култура.
Доставка
Купувача
Моини. Стартова култура. Подходяща за малки и средни по размер аквариумни рибки.
Преглеждания: 1 236
Другите търсят също
Вход
Регистрация
Влез в профила си или се регистрирай, за да не губиш наблюдаваните обяви, търсенията си и следваните потребители – ще ги имаш навсякъде с теб.
Вход/Регистрация